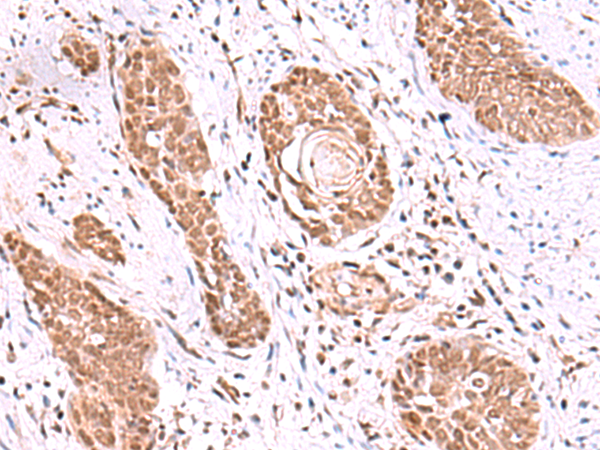

中文名稱: 兔抗RUVBL1多克隆抗體
英文名稱: Anti-RUVBL1 rabbit polyclonal antibody
別 名: RuvB like AAA ATPase 1; RVB1; TIH1; ECP54; TIP49; ECP-54; INO80H; NMP238; PONTIN; TIP49A; NMP 238; Pontin52
相關類別: 一抗
儲 存: 冷凍(-20℃)
宿 主: Rabbit
抗 原: RUVBL1
反應種屬: Human, Mouse, Rat
標 記 物: Unconjugate
克隆類型: rabbit polyclonal
Background:
This gene encodes a protein that has both DNA-dependent ATPase and DNA helicase activities and belongs to the ATPases associated with diverse cellular activities (AAA+) protein family. The encoded protein associates with several multisubunit transcriptional complexes and with protein complexes involved in both ATP-dependent remodeling and histone modification. Alternate splicing results in multiple transcript variants.
Applications:
ELISA, WB, IHC
Name of antibody:
RUVBL1
Immunogen:
Fusion protein of human RUVBL1
Full name:
RuvB like AAA ATPase 1
Synonyms:
RVB1; TIH1; ECP54; TIP49; ECP-54; INO80H; NMP238; PONTIN; TIP49A; NMP 238; Pontin52
SwissProt:
Q9Y265
ELISA Recommended dilution:
5000-10000
IHC positive control:
Human esophagus cancer and Human thyroid cancer
IHC Recommend dilution:
50-300
WB Predicted band size:
50 kDa
WB Positive control:
Raji and K562 cell lysates
WB Recommended dilution:
1000-5000
技術規格

購物車
幫助
021-54845833/15800441009
